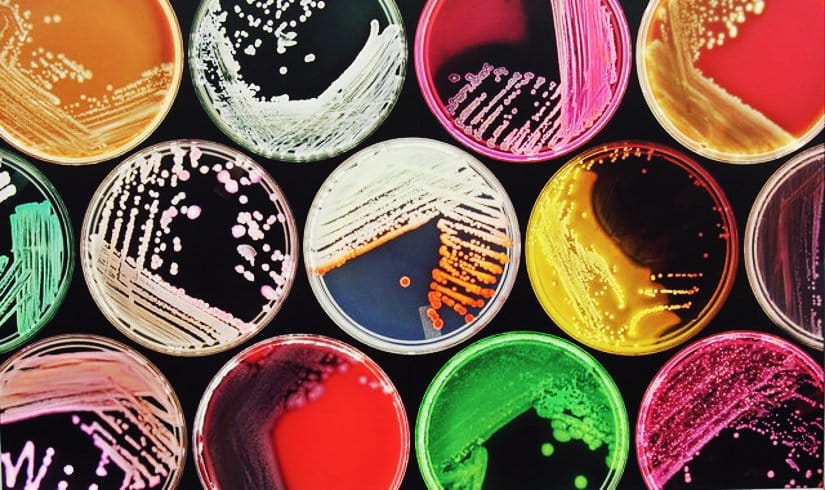
Featured image of post Como limpiar mi computadora de virus, malware y otros bichos

Categories
2026
Buscando la bandeja de trámites en miregistrocivil.gob.mx

Reflexiones inconexas sobre México y su gobierno

Probando NUMA: un DNS local ultrarrápido y fácil de usar

Algo pasó y tu PIN ya no esta disponible

Problemas al crear una USB con Medicat, no recordaba que fuera tan complicado

Instalando una brida flexible para el WC

Exit code 128 al actualizar con yay

Sustituir la batería de un no break

Buscando distribuciones Linux de 32 bits para mi netbook

2025
Encontrando enlaces rotos en el blog con Lychee

Herramientas 'terminal-centristas' Kitty, Yazi, Lazyvim y Lazygit

Jabón Arko para afeitar, económico y cumplidor

La quinta transformación, ahora con HUGO y Cloudflare Pages

Cómo borrar archivos definitivamente de forma segura con herramientas de Linux y Windows

De Elastix a Issabel: Migrando un conmutador telefónico después de más de 10 años de servicio

Consultar tu recibo de luz de CFE ¿Por qué es tan difícil?

Anuncios emergentes en el móvil que no se quitan

De WhatsApp, Open Graph y unas tristes comillas

El comando de Linux MAN: Indispensable que sepas usarlo

Sitio web estático con Eleventy (11ty): Rápido y personalizable.

Automatiza Alertas Climáticas con Python y Telegram: Que nunca más te sorprenda una tormenta

Fases lunares: un programa en Python, un script en Bash y un calendario web

Afeitado para ahorradores extremos (pa codos pues)

2024
Poetry: Indispensable para administrar proyectos con Python

Como reparar una correa de silicona
Prueba Ventoy en Manjaro Linux y simplifica tus instalaciones de sistemas operativos al instante.

Windows XP ¿Sigue vivo? ¿Es posible utilizarlo en la actualidad?

¿Qué es una distribución Linux inmutable?

Código de error: 0x80070035 en OpenMediaVault
Vincular Alexa con Spotify: Un reto inesperado

Aprendiendo React, Mi experiencia.

Desactiva las animaciones de inicio de Manjaro ¡Bye bye Plymouth!

Error reading data from the connection en Microsip

NVIDIA, Nouveau, congelamientos y otras pesadillas.

2023
Series de Fibonacci en Python con estos 3 métodos.

Como arreglé mi lavadora Easy ID System

Cómo calcular Pi con Python: métodos y ejemplos

Mensajes SMS sospechosos, como evitar caer en una trampa

Calcular el área sombreada ¿Importan realmente las matemáticas?

Watchdog en pfSense: Vigila el funcionamiento de los servicios

Actualizar pfSense de 2.6.0 a 2.7.0 ¡Error fatal!

Ganar dinero dando me gusta a videos de Youtube, suena a estafa.
Como cambiar una pila de reloj, una guía para aficionados.

Kernel Panic después de actualizar Manjaro: Initramfs unpacking failed

Cómo desactivar la vista previa de las Tabs en Google Chrome

Mis extensiones favoritas para Visual Studio Code

Una década con Manjaro

2022
¿Tu Equipo Fue Inhabilitado? Intenta quitar el sysDLL

Cómo quitar los anuncios de publicidad en una Smart TV

Como arreglar un foco led fácilmente

NormCap, seleccionar, reconocer, pegar ¡Y listo!

Descargar el tipo de cambio de Banxico con Python

Pantallas azules y reinicios inexplicables de un Windows 7 en Virtualbox

Borrar correos de Gmail para recuperar espacio

Bloquear Facebook, TikTok o cualquier red social usando pfBlockerNG

Obtener la Constancia de Situación Fiscal usando la aplicación SAT ID

LibreOffice Calc: Formato de número telefónico a una celda

Como instalar Manjaro Linux paso a paso, guía para principiantes.

Error al instalar las Guest Additions en Virtualbox : Exit code 2

Convertir todas las imágenes de una carpeta a Webp

Nueve años han pasado desde que instalé Manjaro ¡Y lo que falta!
2021
Como cambiar el color del panel en XFCE
¿Problemas con el hidroneumático? ¡Agua no te acabes!

Función para calcular el ISR anual 2021 en LibreOffice

¡Vámonos de pesca con Fish Shell!

Agregar listas de Pi-hole a pfBlockerNG

Una consulta de MySQL para filtrar datos por día de la semana

Windows 7, Chrome y el error NET::ERR_CERT_AUTHORITY_INVALID

Agregar dominios personalizados a pfBlockerNG en pfSense

Programando una Lotería Mexicana en Python

Mi encuentro con un cronómetro vintage y todo lo que desencadenó en mi mente.

Una aplicación para almacenar coordenadas GPS con MIT App Inventor

La conjetura de Collatz con Python, algoritmo tradicional y recursivo

4 notas sobre OpenVPN en pfSense para conexiones Roadwarrior

Nuevas formas de actualizar Manjaro, Pamac y yay entran al juego

Lazy Load rudimentario para sitios que utilizan Pelican

Acelerar tu sitio web vs Google adsense, no se puede todo en la vida

Cambiando de los drivers propietarios de Nvidia a los libres Nouveau

Python, MySQL y como mezclarlos para hacer consultas

Como arreglar una llave que gotea

La página de Permiso COVID-19 ¿Sirve de algo?

fping para monitorear la salud de las conexiones de red.

Algo anda muy mal con las actualizaciones de Windows 10

pfSense, recuperándome de una falla en el disco duro

Actualizar Manjaro, Failed to start Load Kernel Modules ¡Gulp!

2020
Páginas de error 404 personalizadas en Pelican

Error al obtener la información del descriptor del archivo

Descargar libros de texto gratuitos o cualquier libro similar.

Error al hacer una copia con rsync: File exists (17)

Convertir archivos JPG a WebP con Python

Mat2 una herramienta para eliminar los metadatos de los archivos

Cambiar el lector de libros predeterminado de Calibre

Folding at home, mi computadora ayuda a investigar el COVID-19.

COVID-19 y Python para obtener información sobre la pandemia.

Notable, un programa para tomar notas usando markdown

Peppermint y SliTaz, Linux ligero para equipos viejitos y no tan viejitos.

No se pudo arrancar la entrada predeterminada ni la de reserva.

Dreadnought, brocha, crema de afeitar y bálsamo para después de afeitar.

Rumbos y Azimutales, un script en Python para convertirlos.

2019
Error al unir el archivo, un problema al copiar archivos grandes a una USB.
Exception in thread Unsupported major.minor version 52.0, otra vez Java.

Agarramos la mochila y nos fuimos de paseo al Parque Natural Mexiquillo

Configurar un redireccionamiento de puertos con pfSense

Resucitando a JoliOS ¡Levántate y anda!

Averiguar la dirección IP de un equipo por su hostname.

Automatizando la apertura de Tilix al inicio de la sesión.
El misterio del archivo en formato ASCII, caso de la vida real.
Contraseña para restablecer un celular Lanix U210

Semana de las Tecnologías de la Información BATEIL 2019

Buscar y eliminar archivos en una sola línea con find.

La historia de la tarjeta SIM que no era reconocida por su celular.

Existe en el sistema de archivos : Problema al actualizar Manjaro.
Como agregar tareas a Cron en pfSense

Error de GPGME: No hay datos, un problema recurrente.
Como programar un control remoto Steren RM-2000
Cómo reparar provisionalmente unos lentes de plástico.

Torreón antiguo una comunidad de Google Plus.
pfBlockerNG ayuda a bloquear publicidad, sitios maliciosos y otras amenazas.
Como hacer chroot en Manjaro

2018
Mis inicios con pfSense, comienza la aventura ¡Ahora sin Linux!

S.O.S. Phone In Recovery Mode en un Linksys SPA942

Un juego de ajedrez para niños sencillo y barato.

Descargar videos de Youtube es fácil con youtube-dl

Instalé una regadera eléctrica, esta fue mi experiencia.
Desbloquear el depósito de llaves en Manjaro

Generar un archivo KML a partir de coordenadas GPS con Python

Un recorrido nostálgico por los reproductores musicales de mi vida.
Enviar correos electrónicos con Python

Configurar una impresora LPD en Windows para imprimir desde Linux

Python Ping, un script que revisa las direcciones IP de tu red

Jabón para afeitar elaborado con leche de cabra
La Capilla Sixtina en Torreón
Problemas con KeepassX, Auto-Type y Twitter

Del Paseo Colón a la Ruta Arocena

En época de lluvias, una oración para los truenos.

Correa de reloj hecha con paracord

Puerta trasera abierta en una impresora laserjet 100 color m175nw

Mejorar el tiempo de arranque de Manjaro

El poema de La forma del agua

Convertir imágenes de formato HEIC a JPG con Linux

2017
Configurar WordPress para conexiones HTTPS

Actas de nacimiento por internet ¡Suerte con eso!

Impresora compartida con samba pide usuario y contraseña

Sin espacio en el dispositivo al instalar un paquete con yaourt

Mejorar la descarga de programas desde AUR

Respaldos en Linux, los programas que he utilizado

Conectar una base de datos MySQL con LibreOffice
Varias formas de hacer una USB de arranque

Como reemplazar el audio de un video con software libre

Como reducir de tamaño un archivo pdf ¡Sin morir en el intento!
Como hacer tu propio libro electrónico con software libre
Adiós Elastix, bienvenida Issabel

Pantalla negra después de intentar actualizar Manjaro
Ajustando algunos valores del caché de disco en linux

Adiós al Torreón Moderno, bienvenida terminal Río Nazas
Android casi alcanza a windows como el SO más utilizado en Internet
Problema matemático en Talentos Ocultos
Buscando a Firulais, meme matemático

Cantos para levantar al niño Dios: Los aromas, Venid Pastorcillos

Copiar un sitio web para leerlo fuera de línea
Buscar archivos con catfish en thunar
La Liga Extraordinaria de la lectura

El diálogo de abrir o guardar archivo tarda mucho tiempo aparecer
2016
Clubman Pinaud en México

Problemas matemáticos mal redactados
Obtener el Firmware de teléfonos LG mediante el IMEI
Como arreglar el botón del mouse
Probando rastrillos desechables baratos
Ajustando las opciones de máscara rápida en GIMP
Dial pattern para el 911 en conmutadores telefónicos Elastix
4 puntos clave para un buen afeitado

Agregar texto a una imagen con ImageMagick
Controlar el ancho de banda por dirección IP en Linux

Como arreglar el ventilador de una fuente de poder

Como programar un Control Remoto Universal gowin 4 en 1

Publicidad molesta en mi celular con android
Como reparar fugas de agua en albercas
Como limpiar una memoria usb
El mejor cliente SIP para Android

Mi celular no carga, los puntos que debes de revisar antes de llevarlo a reparar.
Jabón de calabaza como jabón de afeitar

Conflictos entre freetype2 y freetype2-infinality

IPCop sin internet ¡Un misterio por resolver!

Problemas al imprimir en una impresora compartida en Windows desde Linux

Draftsight sin menús y sin barras de herramientas

Fallo de envío al intentar mandar mensajes SMS
Como incluir fórmulas matemáticas en Inkscape
Pacman con Aria2 para descargar los paquetes de Manjaro

wget no se pudo resolver la dirección del equipo

Sonidos divertidos con MIT App Inventor

Como descargar el programa DIOT

¡Haga sus cuentas! El afeitado clásico es más económico

Como sustituir los botones del mouse que no funcionan

Mapa mental: Cómo hacer preguntas de manera inteligente

Spotify con Blockify = música sin comerciales

Algo malo esta pasando con el software de Apple

2015
Fraudes en ventas por facebook

Buscando una figura para el nacimiento

Aprendiendo a generar documentos con LaTeX

La oportunidad detrás del apagón analógico

La bocina de mi celular no se escucha ¡Prueba primero esto!

Hojas de afeitar Super-Max Titanium

Buscar y reemplazar un texto desde la terminal

Bloquear Facebook con las reglas del firewall de IPCop

Estrenando jabón, brocha, shavette y afters

Problemas con la tableta aprende.mx con windows 8.1

Mejores acercamientos con la cámara del celular

De piojos mutantes a mandatos de reyes europeos

Como hacer un meme con inkscape

La bola mágica, un divertido script en Ruby

Windows 10 ¿Gratis? no lo creo, todo tiene un precio

El Centro Histórico de Torreón, un paseo por mis recuerdos

Gillette Super Speed o Gillette Relámpago

El futuro de las salas de cine

¿Quién esta conectado a mi Wifi?

Descargar en una imagen jpg un mapa de Google Maps

Mejorar la señal de un aparato WiFi que no tiene antena

Señal de cruce de peatones
Antena para WiFi EZ-10

Elegir un tema para wordpress

Como limpiar mi computadora de virus, malware y otros bichos
Ajustar Update Accelerator para actualizaciones de Avira

Resolviendo el famoso cubo de Rubik

Buscar si el IMEI de un celular esta como robado en México

Impresora HP p1102w imprime toda la hoja en negro

Ahora estoy usando el editor Atom

Redescubriendo la pluma fuente

Blu Studio 5.5 D610A

Carpetas vacías que ocupan espacio en Linux

Copiar un ISO a una memoria USB con isousb

Actualización de Manjaro abril 2015

La página del CURP no funciona

Revisar una unidad USB con FAT32 en Linux

Problema en el tamaño de la partición en OpenMediaVault

Paquete de muestras de hojas de afeitar

Como hacer un jabón para afeitar

CodeAcademy una buena idea mal ejecutada

Control remoto para Kodi XBMC

¿Problemas con la página del IDSE IMSS? Tips y soluciones

Donde conseguir artículos de afeitado clásico en México.

Función para calcular el ISPT 2014 en Excel y LibreOffice

Imprimir archivos en orden con lpr y Ruby

Construyendo un corazón con Inkscape para el día del amor y la amistad.

Mis 5 jabones para hombre favoritos
Filtros de Instagram en Gimp

Descargar los XML del SAT de una manera más sencilla

xbmctorrent una alternativa a popcorntime

Cambiar el color de la fuente del escritorio en Cinnamon
Hacer un calendario en Inkscape

2014
Imágenes navideñas con Inkscape

Como resolver problemas del reloj en Manjaro

Convertir un lector de memorias interno a externo

Generador de contraseñas con javascript

El problema del archivo db.lck en Manjaro

FreeFileSync una herramienta para sincronizar archivos

Actualizar Microsip con un servidor web local

Como hacer una bufanda para el frío muy sencilla y económica
Soporte para máquinas de afeitar

Como configurar pacman para que utilice wget

Rosetta y Philae, listos para el aterrizaje

Ruby Ping un script para monitorear equipos de red

Lotería Mexicana en Ruby

Escuelas Linux en el estado de Zacatecas

Problemas con la tarjeta Nvidia al actualizar Manjaro

dnsmasq como servidor local de DNS
Limpiar y restaurar una máquina de afeitar

Problemas al actualizar Manjaro

Control de tráfico en IPCop 2

Emergency Mode en los teléfonos LG

Llamadas desde el número 6144069548

Expresiones regulares con Ruby
Zapopan: Visita a tierras tapatías

Aprendiendo con los tutoriales de Inkscape de Art Tuts

Como descargar el firmware de Apple con Aria2

HSBC y su correo de notificación de transferencia de fondos a su favor

El hombre completo

Algunos de mis artículos para el afeitado clásico

Haciendo pruebas con un cable de red redundante

Probar una Fuente de Poder: Consejos y Trucos para un Diagnóstico Rápido

Ya soy inapropiado

Addons y binarios para IPCop 1.4.x

Como configurar un bypass al proxy transparente de IPCop

LXPolKit y su GDBus.Error

Script en bash para encender computadoras remotamente

Actualizando a IPCOP 2

Script en bash que hace ping a tus servidores

De Windows XP a Manjaro Linux con XFCE

Macbook lenta, la solución que me funcionó
Más tips para optimizar Manjaro

El software libre como herramienta para la educación

Como hacer una antena de televisión HD sencilla y económica

Júpiter, Marte y Saturno visibles en el mes de mayo

Aumentar la velocidad de linux con zswap

5 recomendaciones de seguridad en cajeros automáticos

Así fue el FLISOL 2014 en Torreón
Letreros de seguridad con Inkscape

Películas y Series con Flixtor
Así se vio el eclipse lunar (15 de abril 2014)
Eclipse lunar en semana santa
Como arrancar una computadora desde una memoria USB cuando no tiene esta opción
Termina el soporte para Windows XP
De GRUB, fsck y Mi Compu MX
Marte y Júpiter en el cielo del mes de abril
Desactivar la partición de swap
Navegador minimalista en Python
Aumentar el tamaño de la partición root en IPCop 2
swaplabel unsupported swap version '1' en Manjaro (o Arch)
Calcular el determinante de una matriz usando software libre
Como instalar Windows a las Computadoras MX de la SEP

"Shockwave flash has crashed" frecuentes en Chromium - Manjaro Linux
Función que devuelve sólo los números de una celda en LibreOffice

Descargar, ver y subtitular películas en un tris tras con PopcornTime
Ruidos y chasquidos en el conmutador Elastix.
Rsync y Parallel, copias de archivos realmente intensas

Manjaro fussion, Iconos mentolados para distros ecologistas.
Facturas electrónicas falsas
Arreglando GRUB con Boot-Repair
Regresar paquetes a su versión anterior en Manjaro (downgrade).

Problemas con la firma de los paquetes en Manjaro
Teléfono LG Optimus L7 (LG P708g)
AppletFIEL.jar Missing required permissions manifest
Manjaro Netbook Edition
Haciendo la limpieza en Linux con Bleachbit
Códigos para Elastix (Shortcodes)

Habilitar la aceleración por Hardware en Chromium
Instalar mapas de OpenStreetMap a un GPS Garmin

Copiar archivos a mi celular con Android por FTP
Haroopad, otro editor con soporte para Markdown
2013
3 herramientas para detectar memorias USB falsas

Copiar archivos a la microsd del celular en Linux usando MTP
2014 será el año de Linux

Instalar una impresora HP en Linux
Lluvia de estrellas de las Gemínidas
Diciembre, Navidad, Nacimiento y Peregrinaciones

[Solucionado] Ocurrió un error al cargar el tema BlackNBlue
Adiós linuxman.blogsome.com
Instalar el kernel linux-ck en Manjaro
El cometa ISON
MiCompuMX, Linux a la argentina
Configurar Postfix con reenvío de correo (relay mail)

Mi ranking de hojas de afeitar

Calendario Libre 2014
Brocha para pintar como brocha de afeitar ¿Es posible?

La coca cola ahora con jarabe de maíz

Conflictos con libdbusmenu-glib al actualizar Manjaro
Prueba Manjaro Linux
Calaveritas 2013
La inseguridad en la Comarca Lagunera

Se pierde la configuración del teclado después de actualizar Manjaro Linux
Duplicati, una herramienta para hacer respaldos
Consultar la wikipedia sin internet
Demo en línea de CodekaMX
Como descargar libros electrónicos gratis

Configurar un servidor de correo Postfix con DKIM y SPF

FreeNAS vs NAS4Free vs OpenMediaVault

Descargar Manjaro Linux por torrent
Los remedios de mi abuelita
Bloquear facebook con IPCop + iptables

Edición de video en Linux: Openshot y Kdenlive
HSBC OpenDNS ¿Malware?
Haciéndola de plomerito
Smath Studio: Ayuda con las matemáticas.
¿TIC en las escuelas o materia de computación? Este cuestionario le ayudará a averiguarlo

La SEP elige a Linux para sus laptops
Celular chino no sincroniza los contactos con Gmail
Ajustar el volumen a los mp3 con mp3Gain
De navajas, jabones, lociones y otros accesorios de afeitado
Squid local en Manjaro
Chácharas y Juguetes
Instalando un DNS Caché en Manjaro
Premio: Los 7 pecados capitales de la lectura
Iconos planos (flat icons) para LibreOffice en Manjaro
Política hasta en Squid: LRU, LFUDA, GDSF
Foros de Manjaro Linux en Español

Controles Faience + Iconos Elementary = Woooow
Plugin Beautify para Gimp o retoque digital para flojos

Cinnamon Fallback Mode en Manjaro
Richard M. Stallman en Torreón.
Bosque Urbano de Torreón

Ordenamiento rápido (Quick sort) en Ruby
Ordenamiento de burbuja en Ruby
Script para respaldar bases de datos MySQL versión 2

De pajaritos, chismes y redes sociales
No aparece la opción de comprimir una carpeta en Nemo
Serpientes y escaleras: 100 casillas de diversión
Adaptar un ventilador de CPU Intel para un AMD
Eliminar paquetes que no son necesarios en Manjaro

La odisea de conseguir hojas de afeitar

Spotify en Manjaro
Manjaro 0.8.5 ha sido liberado
Paleta de colores de Manjaro

Como saber si un celular fue mojado

MariaDB y Microsoft Access
Optimizar archivos PNG y JPG
¿Cómo se calcula la Semana Santa? ¡Siempre cae en luna llena!

Octopi, otra interfaz gráfica para pacman en Manjaro
Uso de software libre en el gobierno mexicano
Como quitar el buscador personalizado de Linux Mint
Missing Operating System en Windows 7

Afeitado clásico con navaja de barbero
Pamac sustituye a pacman-gui en Manjaro 0.8.4
Ya esta disponible Manjaro Linux 0.8.4
Allservers.sh : Un script para actualizar Manjaro Linux
Mostrar el clima en Conky con RSS
Administrar las aplicaciones al inicio en Cinnamon
Instalar NTP en Windows para resolver problemas de hora en Manjaro

Como recortar una tarjeta SIM a NanoSIM para el iPhone5

Synapse y Zeitgeist en Manjaro Linux
Montar automáticamente compartidos de red windows en Manjaro Linux
No aparecen las computadoras de mi red windows
Vestido del niño Dios 2013
Problema para imprimir en impresoras compartidas de windows en Manjaro [Solucionado]
Faltan las carpetas Descargas, Documentos, Imágenes, Música y Videos en Manjaro
Pago de refrendo vehicular en Gómez Palacio
2012
Primeros pasos con Manjaro Linux
Calendario Maya e historias del fin del mundo
Manjaro Linux y la tarjeta gráfica GMA500 (poulsbo)
Creando una USB de arranque para Manjaro
Respaldar un sitio web con wget

Como generar documentos digitalizados para la ventanilla única

Update Accelerator, mejorando las actualizaciones con IPCop
Focos LED al fin disponibles en México
Recuerdos del centro de cómputo del ITL
Escribir sin distracciones: FocusWriter y Uberwriter
ClamAV no actualiza la base de datos de virus.
El final de Abismo de Pasión
Alineación de planetas con las pirámides de Egipto
Corregir el formato de número Español México en Ubuntu
Problema con el ODBC de MySQL en Windows 7 de 64 bits

Desde Hotmail hasta Outlook
Obtener el IMEI para reportar celulares robado o extraviados

Como reiniciar el servidor gráfico en Ubuntu
Convertir todas las imágenes de un directorio a PDF

Consejos para una navegación segura en internet
Cargador de pilas alcalinas y recargables
CrunchBang Linux en una Acer AO751h
Parras de la Fuente, Coahuila.

La Plaza Mayor de Torreón
Descargar Ubuntu 12.04 LTS Precise Pangolin por bittorrent
Script para respaldar todas las bases de datos de un servidor MySQL
Cambiar los archivos temporales de Chrome a un disco en RAM
Maximizar el uso de la memoria RAM
La veneración a los idiotas
Mis aplicaciones favoritas para Android (segunda parte)
Puente Solidaridad en Torreón Coahuila
Como descargar el SUA más actualizado
El final de "La que no podía amar"
Nextgen Gallery, mostrar el ALT text como título de la imagen
Como localizar a la estación espacial internacional
Planetas Visibles Febrero 2012 Mercurio, Marte, Venus y Júpiter
Cómo Reciclar tu iPod viejo como Unidad de Respaldo
Como formatear una memoria usb en linux
winPenPack, aplicaciones libres en tu memoria usb
Función en Excel para calcular el ISPT anual
Porqué el cierre de Megaupload no afecta al software libre
CodekaMX, cuando el software libre deja de serlo.
Las Grutas del Rosario

Ma y Pa Drácula de Ann M. Martin
JoliOS 1.2 en la Acer AO751h
2011
Los subtítulos muestran letras raras
Un acordeón para Luakit
Luakit un navegador minimalista realmente ligero
Wicd en ubuntu con lxde
El Cine Nazas en Torreón
VNC Client en Puppy Linux
La Inmaculada Concepción de Jerez Zacatecas
Configurar la tarjeta GMA500 para dos monitores
A mi también se me olvidan los autores de los libros
Rooteando el Huawei U8150 IDEOS de Unefon
El Tradicional Nacimiento Navideño
Mejorando la duración de la batería con Jupiter
Cambiar las imágenes a otro dominio con SQL en Wordpress
Número con letra, una función para LibreOffice Calc

Migrando de blogsome a wordpress
Script en Python para averiguar la contraseña por default de los Infinitum Huawei
Acer Aspire One AO751h con Linux Mint 11 LXDE
Administrando conexiones remotas con Remmina
Mis aplicaciones favoritas para Android

Qalculate! Una calculadora para Ubuntu.
Dudas sobre las actualizaciones de Ubuntu
Aquí tienen algunos consejos para ahorrar tinta, papel y tóner

Aumentar el rendimiento con zRAM
Notificación de Correo en Ubuntu
Problemas con ADW Launcher en Android
Como configurar un teléfono CISCO Unified IP Phone 9951 con Elastix

Programa en Python para descargar imágenes de una página web

Edición de imágenes por lote con Gimp (Batch Image Processor)
Arranque de ubuntu optimizado con e4rat
Axel acelerador de descargas
El final de la Fuerza del Destino
Samsung Galaxy Ace GT-5830L
Como restaurar un respaldo en Elastix

Ingeniería Electoral Aplicada
Calamaris + IPCop
El puente de las palmeras mochas
LiLi, Linux a donde vayas
A donde el rey va solo

spoolsv.exe hace lenta la computadora
Acer AO751h y el driver EMGD
Jugar Ajedrez en Linux
Rastreador de tormentas y huracanes
Dial plan para llamadas locales
Foro en el Senado: Software libre en México

El juego "Adivina el número" en Python
Segundo Congreso Internacional de Software Libre
IPCop y los Delay Pools de Squid
Como conectar IPCop a Infinitum
Pláticas de antaño, un libro lleno de anécdotas de Jerez Zacatecas
Problema con las tarjetas Broadcom BCM43xx en Ubuntu 11.04

Listo para descargar Ubuntu 11.04 natty narwhal
Tradicional Quema de Judas en Jerez Zacatecas
Múltiples líneas en la descripción de los artículos
El Flisol 2011 en Plaza 4 Caminos
Encom Linux Console
Administrar conexiones remotas con PAC Manager
FLISOL 2011 en Torreón
Unefon IDEOS, El Android de los pobres
Rails para Zombies
DraftSight, Software CAD para Linux
OpenShot, un editor de video
El Final de Teresa
Las 11 canciones de Megamente

Bolsas reutilizables
Preparativos para una helada

Frío en la Comarca Lagunera
Olimpiada Mexicana de Informática 2011
Ajedrez para niños

Como hacer un germinador casero con cartón de huevo
No se encontró el candado Microsip (H0007)

Errores al validar los CFD en la página del SAT
Gran Danés Arlequín o el Perro de Lady Gaga
2010
Refacciones para licuadoras Moulinex
Feliz Navidad y próspero año 2011
Samsung Galaxy S vs. Nexus S
IPCop + OpenVPN (Zerina) + Roadwarrior + Ubuntu
Facturación Electrónica Libre
DebPBX, VoIP en Debian.
Cache DNS
Instalar Squid localmente en Ubuntu
PixieLive para netbooks con chip GMA500 (aka poulsbo, psb)
Centro de entretenimiento con una Acer Revo
La vuelta de la muerte
10k Victoria 2010
¿Se ha olvidado la buena ortografía?
Ubuntu Font en Windows y Chrome
Estrellas del Bicentenario COAHUILA
Bittorrents de Ubuntu 10.10 "Maverick Meerkat"
Enviar faxes por el servidor Hylafax de Elastix
Acer Aspire One AO751h con Jolicloud
Jalar una llamada de un conmutador Elastix

Resident Evil Afterlife
DraftSight, una alternativa para Autocad
Cuarto Congreso Internacional de Software Libre
Facturación electrónica Verdades y Rumores
Grandstream Handtytone 286 en Elastix
Como abrir Hulu y Pandora desde México
Problemas con el iPod y el iTunes
Mi primera distro, Caldera OpenLinux
3 consejos SEO para blogsome
Aplicaciones portátiles para Linux
Nuevamente corre el agua en el vado del Río Nazas (2010)
Instalando Lubuntu
SFLphone, Soft Phone para Linux
Como configurar un SPA922 para un conmutador Elastix

Problemas para abrir Facebook en Chrome y Firefox
Raymundo Beach, en el parque nacional Raymundo.
Construyendo un conmutador telefónico con Elastix

Buscando vulnerabilidades con Nessus
El mundial con Google Chrome
El mundial con Google Wave : México vs Francia
Samsung Tocco o S5560
Sobre el CanonMX, mis impresiones
Hongos en los CD
Convertir y reproducir archivos WebM de video
Modificar el valor autoindex de Mysql con phpMyAdmin
Ubicación del Territorio Santos Modelo (Nuevo Estadio Corona)

Monitorear el ancho de banda con IPCop e IPTraf
No puedo sincronizar aplicaciones en el iPad (Solucionado)
4 pasos para preparar a Ubuntu para el uso diario
Montar una carpeta de red compartida de Windows en Linux
Ubuntu 10.04 Lucid Lynx , al fin ha sido liberado
Desde el Flisol 2010 en la UAC
Google Street View en la Comarca Lagunera
Teamviewer para Linux
Los beneficios del software legal
Registrar tu teléfono celular
Como orientar una antena de Dish en México
Un script para convertir videos a formato avi y pegar subtítulos en linux

TRON Legacy
El Metroparque: Proyecto en el lecho del Río Nazas
Eliminar los kernels instalados con Ubuntu Tweak
Mejorando retratos con GIMP
Tacos de perro en Torreón
Letrero de alta tensión
Como recuperar GRUB 2 después de instalar Windows
Como separar la parte entera de un número y sus decimales en PHP

Esto es México, Estrellas del bicentenario
Video tutoriales de GIMP
Marte muy cerca de la luna (Enero 2010)
CODEKA MX, sistema de facturación web para México
Como evitar que vean mi lista de amigos en facebook
Como hacer una lámpara LED con una serie navideña
Un editor para trabajar en PHP , Komodo Edit
Como configurar la ciudad del clima en Enna Media Center
Enna, Media Center Open Source
Panteón de Dolores en Jerez Zacatecas

symb_os v9.3.1 en Fringe
Hermano en la tierra
2009
El robo de bronce en la Comarca Lagunera
Icono al estilo de Adobe CS4 pero con inkscape
Muere Arturo Beltrán Leyva
Ink la película
Disminuir el acceso al disco duro : swappiness
Ubuntu One
Proyecto Calendario Libre 2010
Sobre el CRIT y el Teletón
SETI@Home: Búsqueda de Inteligencia Extraterrestre en casa
Inseguridad en Torreón, 5 minutos de pánico
LXDE un entorno de escritorio ligero
Pruebas de Hardware a un Blackberry
Fallo al obtener la lista de compartición del servidor - Ubuntu Karmic Koala
Territorio Santos Modelo
Moovida Media Center
Administrar GRUB 2 en Ubuntu Karmic Koala
A bajar Ubuntu 9.10 Karmic Koala
Haciendo olas con Google Wave
Los chistes de Fernando del Solar
I love Droid Font
Probando Windows 7
Equipos Maltratados
Cuando MySQL confunde la ñ con la n
Chevrolet Silverado
EL bendito winmail.dat
Billetes en la cartera
Puppy Linux es la onda
Tercer Congreso Nacional de Software Libre
Rescatando al soldado IPCop
Montar particiones NTFS con Trinity Rescue Kit
Mi esposa sobrevivió al Seguro Social
Google Chrome con soporte para temas
El maestro del mal de Jim Hougan
Canción del administrador de sistemas
URLFilter en IpCop, acceso a usuarios por direccion IP
Quinto Aniversario de este blog
Creando un logo para twitter laguna
Como hacer una regadera usando una tapa de refresco
Consejo para ahorrar agua en el inodoro del baño
Norton Internet Security no permite abrir páginas en Explorer o Firefox pero si el MSN
Mejorando la casa: Modificando un aire acondicionado
Twitter recargado con greasemonkey
Problemas para actualizar JDownloader
Ubuntu con 4 GB en RAM
Gantz
Chrome sin publicidad
Visite Jerez , o como conseguir fotos fácilmente en Flickr
Flisol 2009
Screenshot Ubuntu Jaunty Jackalope
Disponible Ubuntu 9.04 Jaunty Jackalope
MySQL Tuner, Un asesor en el rendimiento de servidores MySQL
¿Cómo buscar campos duplicados en Mysql?
El colmo con Bancanet
Los Jacales en Peñon Blanco Durango

Museo General Francisco Villa
Horario de verano, a ajustar los relojes
Agil, cómodo y seguro - el estacionamiento de Abastos de Torreón
Buscar la disponibilidad de dominios sin que te los ganen
Cultura y software libre - Jornadas TIC
Perdida de conexión a un servidor MySQL mediante ODBC y MS Access
Instalando Enlightenment en Little Star
Jornadas de Educación y TIC
Instalando Ubuntu sin CD - netinstall
JDownloader, para bajar archivos de Megaupload y Rapidshare
El wallpaper de la lámpara
Coraline
Recuperando un Sony Ericsson W580i que no enciende
MusicTracker, poner la música que escuchas en Pidgin
Casi famoso
Trinity Rescue Kit en busca del virus maldito
Por donde pasa el Presidente
El famoso Pitirijas, el terror de las viejas fisgonas

No se pudo obtener el libro de direcciones de MSN
Antes del MP3
Jerez Zacatecas Pueblo Mágico
2008
Rescatar un celular mojado metiéndolo en arroz

A respaldar que el mundo se va a acabar
Santos Archivos Eliminados
Ajustando la codificación de caracteres en Samba
Bloqueando el messenger con IPCop - El enfoque OpenDNS
Una VPN net2net usando IPCop y OpenVPN
Puentes a prueba de agua
Atardecer en el río Nazas
No carga la batería del Blackberry
La llegada del Nazas

Resetear contraseñas de Windows con Trinity Rescue Kit
Ba-k.com ahora como Bakunos.com
Cuando no tienes la contraseña de la computadora con Windows
Piporro y La nave de los monstruos
Como hacer unas pesas de cemento

Como configurar una VPN con IPCOP
Pancho Villa una biografía narrativa, el mejor libro sobre Francisco Villa

Aumentando TX Power
Entre el ángel y el fierro, Francisco Villa
IPCop y OpenDNS
Gnome Do en PCLinuxOS
Mis experiencias usando DD-WRT en un equipo WAP54G
La Concha Country Club

Monumento a Francisco Villa en Gómez Palacio Durango

Auditando contraseñas WEP en 7 pasos.
Problema con GRUB, Falta NTLDR
Cambiando el firmware de un WRT54g a DD-WRT
Cómo apoyar el software libre sin ser un activista

La antena del escurridor de aluminio para el Wifi
Memorias de Pancho Villa
Cuando la CURP no se encuentra en la base de datos

Como comprar memoria para una portátil

Como hacer un irrigador casero para el jardín
Vaya y visite el Puente de Ojuela en Mapimí Durango

2007
Antenas baratas 2, La EZ-12
Inguanzo
El comportamiento del software
Adaptador USB Wireless ENUWI-G2 de Encore con Ubuntu, la solución que me funcionó.
Extensión remota del conmutador usando SPA3102 (o Sipura 3000)
Arreglar una imagen torcida con GIMP
Museo del Ferrocarril en Torreón Coahuila

Generar un marco para las imágenes con GIMP
Cambiar el color de los ojos con GIMP en menos de 3 minutos.
Astronomía para aficionados

El vestidito del Niño Dios
2006
Cingular 8125 se niega a arrancar (o problemas con la batería)
Trabajando con ipCop

La Historia del Chanate Radioactivo

El final de amor en custodia
El eterno misterio de saber cuanto cobrar por un proyecto

¿Cuál fue tu primer computadora? aquella que recuerdas con cariño

Como configurar un enlace inalámbrico usando equipos Linksys WAP54G

Conferencia y Taller de Linux en el ERSIC 10
Combinar archivos de texto en Windows y en Linux

Lo mejor del PatasWare, El SUA

El problema es la elección, Windows, Linux u OSX




